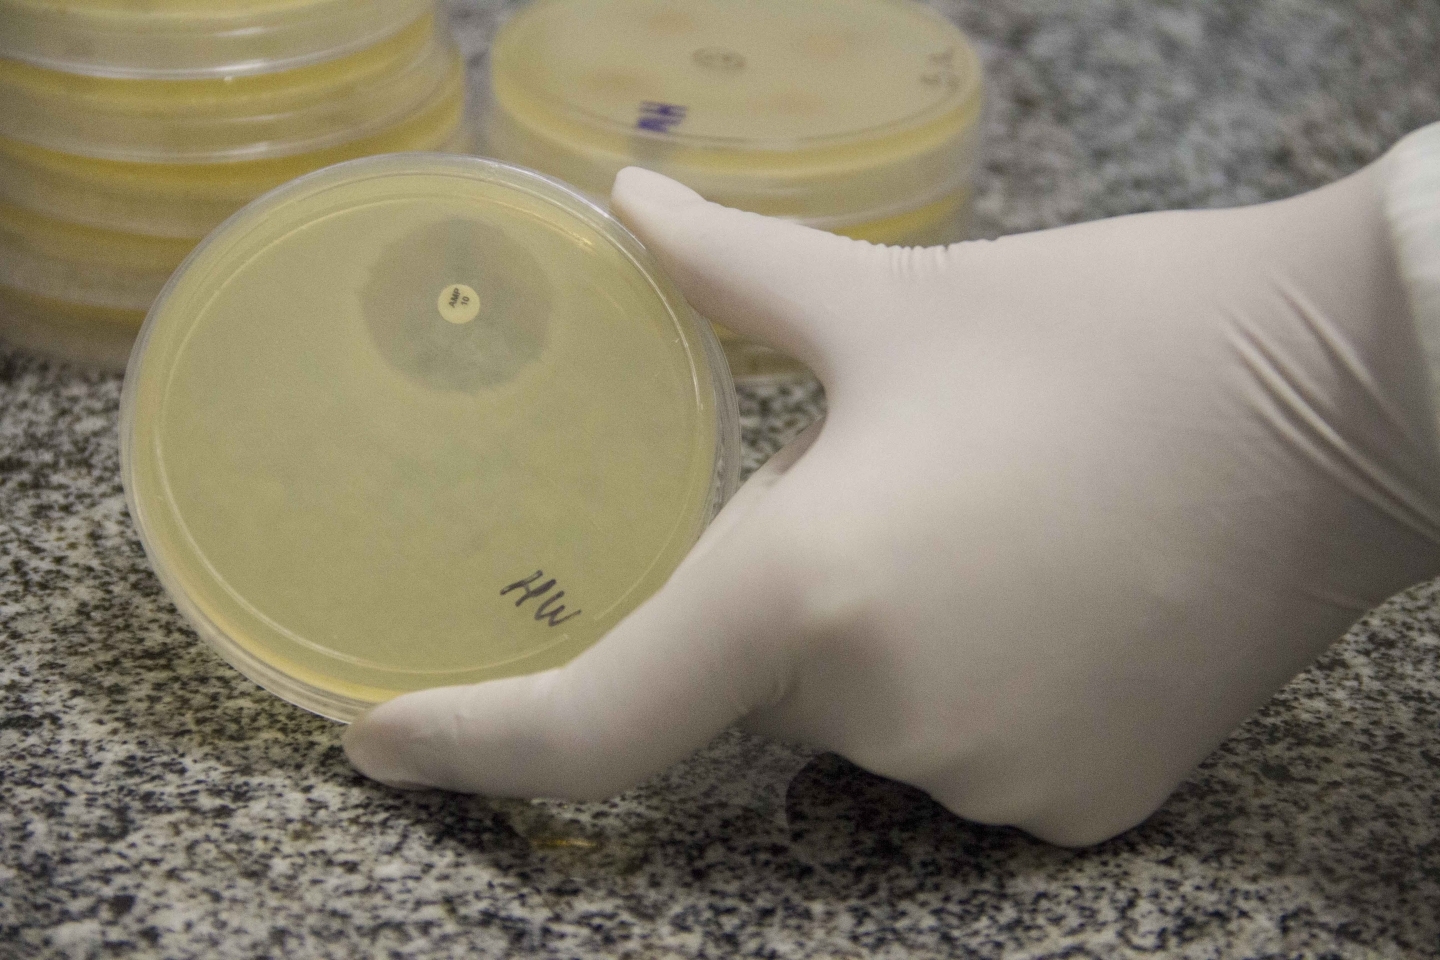
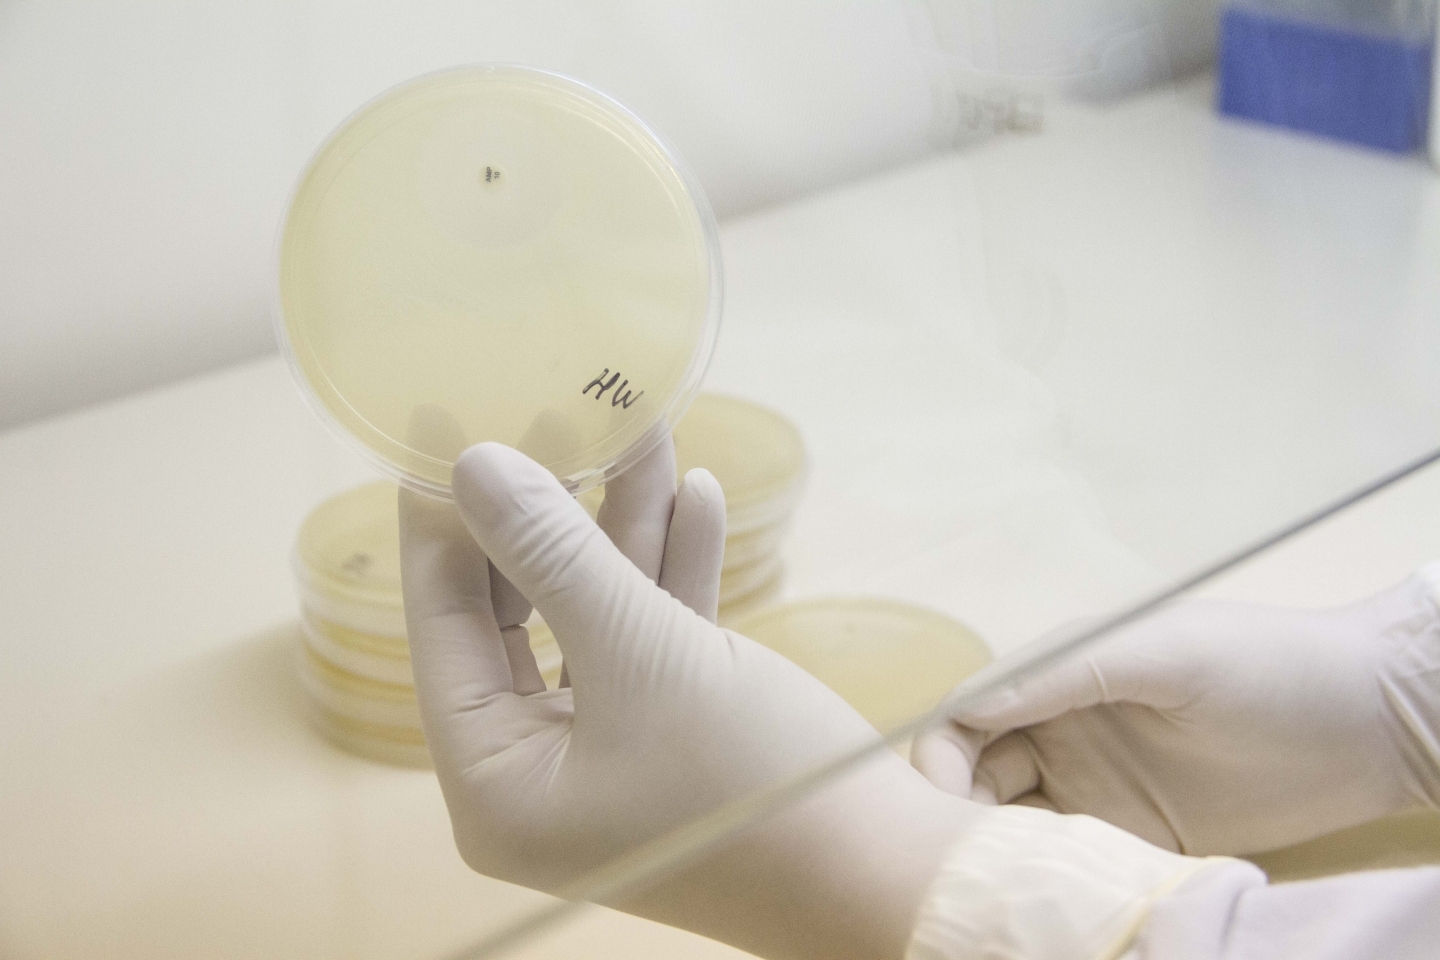
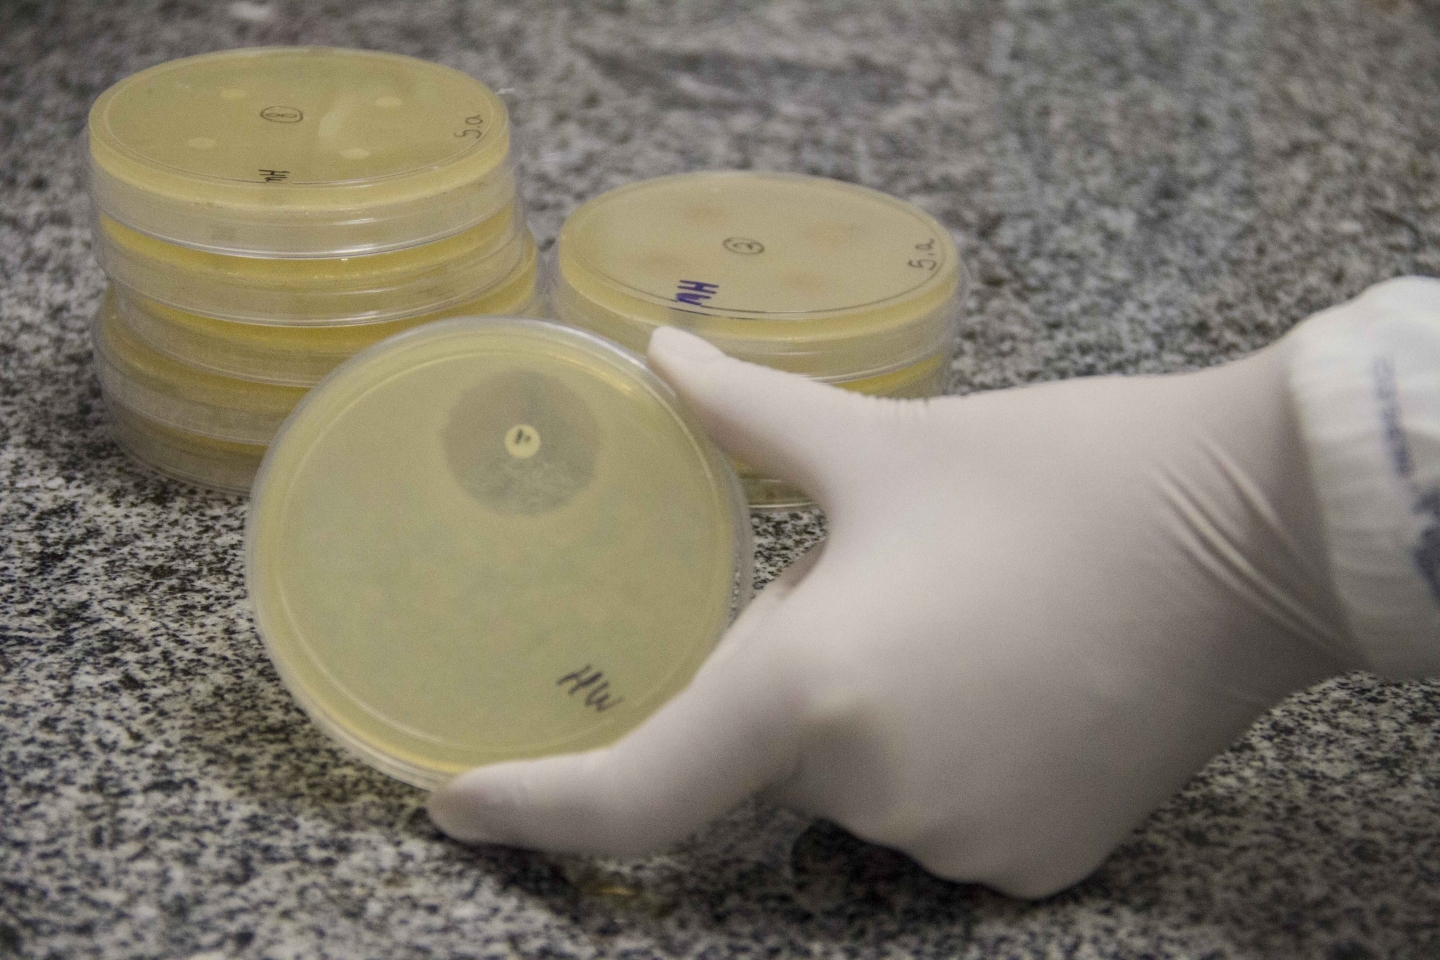

O aumento do número de microrganismos resistentes a diversos antibióticos é alarmante, o que ocasiona o aumento de doenças de difícil tratamento que podem, muitas vezes, levar o indivíduo à morte. Além disso, diferentes microrganismos utilizam diferentes estratégias e ferramentas moleculares para infectar e resistir no hospedeiro. É justamente para caracterizar diferentes microrganismos patogênicos e identificar novas e potenciais moléculas com atividade antimicrobiana que é realizada, no Programa de Pós-Graduação em Biotecnologia da Univates (PPGBiotec), a pesquisa ?Caracterização molecular e controle de microrganismos de importância médica?, coordenada pela professora Dra. Lucélia Santi.
?Neste projeto identificamos e caracterizamos os mecanismos relacionados à infecção e resistência no hospedeiro, além da busca de diferentes atividades antimicrobianas a partir de extratos naturais de diversas fontes, como folhas, sementes e óleos essenciais de plantas, além de extratos microbianos. É uma abordagem importante associada ao uso da nossa grande biodiversidade em busca de novos compostos para combater microrganismos causadores de infecções importantes em humanos e em outros animais?, explica Lucélia.
Além de avaliar a atividade dos extratos vegetais sobre os microrganismos, os pesquisadores estudam o efeito deles sobre um importante fator de virulência microbiano: os biofilmes. Segundo Lucélia, o termo biofilme refere-se a comunidades de microrganismos, de uma ou mais espécies, que se aderem a superfícies, protegidos por uma matriz extracelular que permite a sobrevivência em ambientes hostis. ?É sabido que, quando presente em biofilme, um microrganismo torna-se até 1000 vezes mais resistente aos agentes antimicrobianos, estresses ambientais e mecanismos de defesa imune do hospedeiro. Ainda, estima-se que 65% das infecções microbianas em seres humanos são causadas por microrganismos que se multiplicam em biofilmes aderidos a diferentes superfícies, sejam elas dentes, ou implantes, como válvulas cardíacas, cateteres e próteses?, afirma a pesquisadora.
A pesquisa também busca identificar fatores de virulência microbianos em nível molecular que favorecem a permanência do microrganismo no hospedeiro e na forma de biofilme, principalmente por meio de ferramentas proteômicas. O estudo tem colaboração internacional com os institutos de pesquisa americanos The Scripps Research Institute e Sanford-Burnham-Prebys Medical Discovery Institute (La Jolla - Califórnia - Estados Unidos) e nacional com o Hospital de Clínicas de Porto Alegre, além de pesquisadores do PPGBiotec. Mais informações sobre o PPGBiotec podem ser obtidas pelo telefone (51) 3714-7037 ou pelo e-mail ppgbiotec@univates.br.
Texto: Nicole Morás